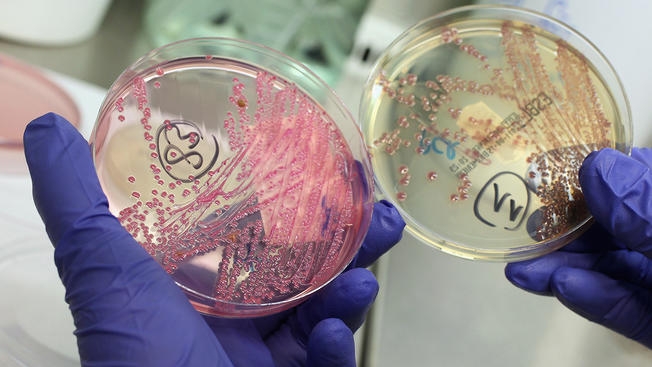
my bung phat dich ecoli

| TIN LIÊN QUAN | |
| Mỹ: Báo động dịch sởi hoành hành trở lại | |
| Ấn Độ lo ngại tình trạng các ca nhiễm virus Zika không ngừng tăng | |
Cơ quan y tế liên bang Mỹ cho biết các trường hợp nhiễm khuẩn E.coli được ghi nhận tại các bang Ohio, Kentucky, Tennessee, Virginia và Georgia trong đó 8 người đã phải nhập viện.
Các trường hợp nhiễm E. coli O103 được ghi nhận từ ngày 2 – 29/3 và đây là một chủng đặc biệt. Những người bị nhiễm bệnh có độ tuổi trung bình là 17, trong đó ít tuổi nhất là trẻ 1 tuổi và cao nhất là bệnh nhân 74 tuổi.
![]() |
| Các trường hợp nhiễm E. coli O103 được ghi nhận từ ngày 2 – 29/3 và đây là một chủng đặc biệt. (Nguồn: NBC News) |
Các triệu chứng nhiễm E.coli được CDC công bố bao gồm co thắt dạ dày, nôn mửa và tiêu chảy. Hầu hết bệnh nhân đều khỏe hơn trong vòng sau 5 - 7 ngày, tuy nhiên bệnh có thể diễn biến xấu và một số trường hợp thậm chí đe dọa đến tính mạng.
Hiện cơ quan y tế liên bang Mỹ vẫn chưa xác định được chính xác loại thực phẩm, cửa hàng hoặc chuỗi nhà hàng cụ thể nào chịu trách nhiệm về việc lây lan khuẩn E.coli. Do đó, CDC chưa đưa ra khuyến nghị người dân nên tránh sử dụng một loại thực phẩm cụ thể nào.
CDC đang phối hợp với Cục Quản lý thực phẩm và dược phẩm Mỹ (FDA), Cục kiểm tra an toàn thực phẩm (FSIS) thuộc Bộ Nông nghiệp Mỹ để điều tra vụ việc.
Năm ngoái, một vụ bùng phát dịch E.coli liên quan đến rau diếp đã khiến 62 người mắc bệnh ở 16 tiểu bang của Mỹ.
| Canada bùng phát dịch do nhiễm khuẩn E.coli từ rau diếp đảo Kos Ngày 22/12, Cơ quan Y tế cộng đồng Canada cảnh báo đợt bùng phát dịch do nhiễm khuẩn E.coli mới diễn ra tại quốc gia ... |
| Bùng phát dịch tả lớn nhất trong lịch sử tại Yemen Ngày 13/10, Liên hợp quốc (LHQ) đã đánh giá tình hình dịch tả hiện nay tại Yemen là đợt bùng phát dịch lớn nhất từng ... |
| Mỹ: Nguy cơ bùng phát dịch bệnh từ sự suy giảm đàn dơi Giới chức y tế Mỹ đang lo ngại một căn bệnh lạ làm chết đàn dơi có thể dẫn đến nguy cơ bùng phát dịch ... |